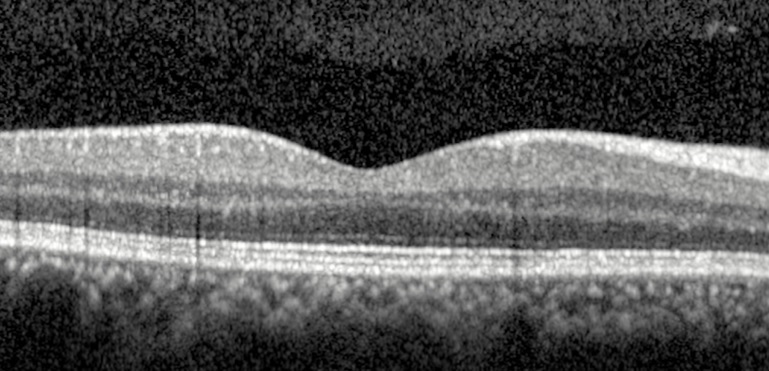

Como se da o processo de Interferometria de Baixa Coerência?
A Inferometria de Baixa Coerência é o princípio por traz do funcionamento da Tomografia de Coerência Óptica (OCT) e funciona da seguinte forma:

Quais são os diferentes tipos de OCT, considerando sua tecnologia, e suas respectivas características?
1. Time-Domain
2. Spectral-Domain
3. Swept-Source

Quais estruturas podemos identificar num exame de OCT sem alterações?

Como podemos identificar qual olho está sendo apresentado em uma imagem B-Scan de um corte horizontal de OCT?
Caso o Nervo óptico não esteja evidenciado, podemos observar a camada de fibras nervosas da retina, já que, nos cortes horizontais, ela se espessa em direção ao disco óptico. Assim, se a Camada de Fibras Nervosas da Retina torna-se mais espessa a direita da fóvea, quando olhamos a imagem, temos um olho direito.
Quais são as principais alterações que podem se manifestar com Hiporrefletividades no OCT?
Quais são as principais alterações que podem se manifestar como Hiper-refletividade?
Quais doenças da Interface Vitreorretiniana estão evidenciadas nas imagens abaixo?

Quais os principais achados nos exames abaixo?

Qual é o princípio de fundionamento do OCT Angiography (OCTa)?
O aparelho de OCTa funciona de forma semelhante ao OCT convencional gerando imagens de A-Scan e B-Scan.
EN-FACE: Contudo, através da tecnologia En-Face ele consegue realizar segmentações desses scans em diferentes planos, gerando imagens decamadas específicas dentro da retina e coróide.
DETECÇÃO DE HEMÁCIAS: Para avaliar a existência de vasos, o aparelho faz diversos scans em um mesmo ponto e compara essas imagens: Nos locais onde existem vasos, alguns scans vao atingir as hemácias em movimento e outros vão passar entre as hemácias, gerando imagens diferentes do mesmo ponto. Assim o aparelho distingue local com e sem vasos.

O exame de OCTa é um exame estático ou dinâmico?
Estático.
Apesar do aparelho realizar diversos scans em momentos diferentes, para detectar o movimento das hemácias, o resultado do exame em si representa um único momento e, portanto, o exame não é dinâmico (como é, por exemplo, a angiografia com fluoresceína)
Quais são são os níveis de segmentação avaliados no OCTa?
1. Complexo Vascular Superficial
2. Complexo Vascular Profundo
3. Complexo Avascular
4. Coriocapilar

Quais são as principais indicações para o uso do OCTa?
Quais são as alterações apresentadas nos exames de OCTa dos dois casos da figura abaixo?

Caso 1.
Caso 2.
Quais são as vantagens do OCTa em relação à Angiografia com a Fluoresceína?
Quais são as desvantagens do OCTa em relação à Angiografia com a Fluoresceína?
Quais são os principais artefatos que podemos encontrar no exame de OCTa?
